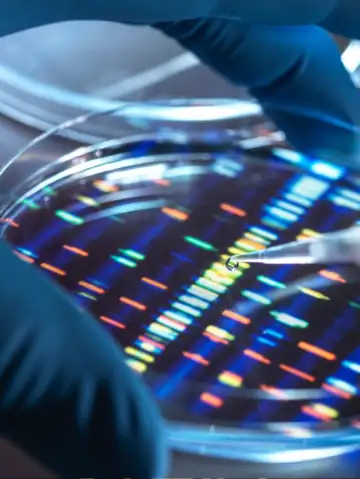

Predicting Effective Treatments: ML analyzes patient data to predict the best treatment, reducing risks of adverse reactions.

Analyzing Multi-Omics Data: ML processes multi-omics data to predict outcomes for individuals and populations.

Boosting Genomics Research: ML aids in DNA sequencing and identifying genetic variations for better research.
Personalizing Medicine Approaches: ML develops personalized treatment plans for complex diseases like inflammatory conditions.

Mimicking Physician Decisions: ML models help replicate physician decision-making to improve healthcare access.

Adapting Treatments to Patients: ML enables treatments to adjust based on patient response, improving outcomes.



